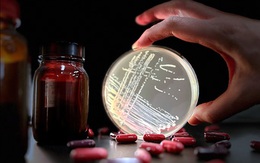
Xác định loại kháng sinh phổ biến có liên quan đến siêu vi khuẩn nguy hiểm

Vui lòng nhập Tên hiển thị
Vui lòng nhập Email
Email Không đúng định dạng
Vui lòng nhập Email
Email Không đúng định dạng
Mật khẩu không đúng.
Thông tin đăng nhập không đúng.
Tài khoản bị khóa, vui lòng liên hệ quản trị viên.
Có lỗi phát sinh. Vui lòng thử lại sau.
Nhập mã xác nhận
Đóng lạiVui lòng nhập thông tin và ý kiến của bạn
XThêm chuyên mục, tăng trải nghiệm với Tuổi Trẻ Sao
Từ ngày 1-1-2023, Tuổi Trẻ Online giới thiệu Tuổi Trẻ Sao - phiên bản đặc biệt dành riêng cho các thành viên với nhiều chuyên mục và trải nghiệm thú vị, bao gồm: Tư vấn pháp luật, Hỏi chuyện sức khỏe; Xem nhật báo sắc nét trên mạng (E-paper), Tuổi Trẻ Live (trực tiếp các sự kiện thời sự nóng bỏng, hấp dẫn).
Tuổi Trẻ Sao được thiết kế thông thoáng với tất cả các trang, chuyên mục và video đều không có quảng cáo hiển thị, không làm ngắt quãng sự tập trung của bạn đọc.
Bằng cách đóng góp Sao, thành viên Tuổi Trẻ Sao có thể tham gia các hoạt động và tương tác trên nền tảng Tuổi Trẻ Online như tặng Sao cho tác giả và các bài viết yêu thích, đổi quà lưu niệm trong chương trình, đăng ký quảng cáo, mua sắm trực tuyến.
Báo Tuổi Trẻ phát triển Tuổi Trẻ Sao nhằm từng bước nâng cao chất lượng nội dung, tăng khả năng kết nối, tương tác và thực hiện các nội dung mới theo nhu cầu của số đông công chúng.
Chúng tôi hy vọng Tuổi Trẻ Sao sẽ góp phần chăm sóc, phục vụ và mang lại những trải nghiệm mới mẻ, tích cực hơn cho cộng đồng độc giả của Tuổi Trẻ Online.
TTO